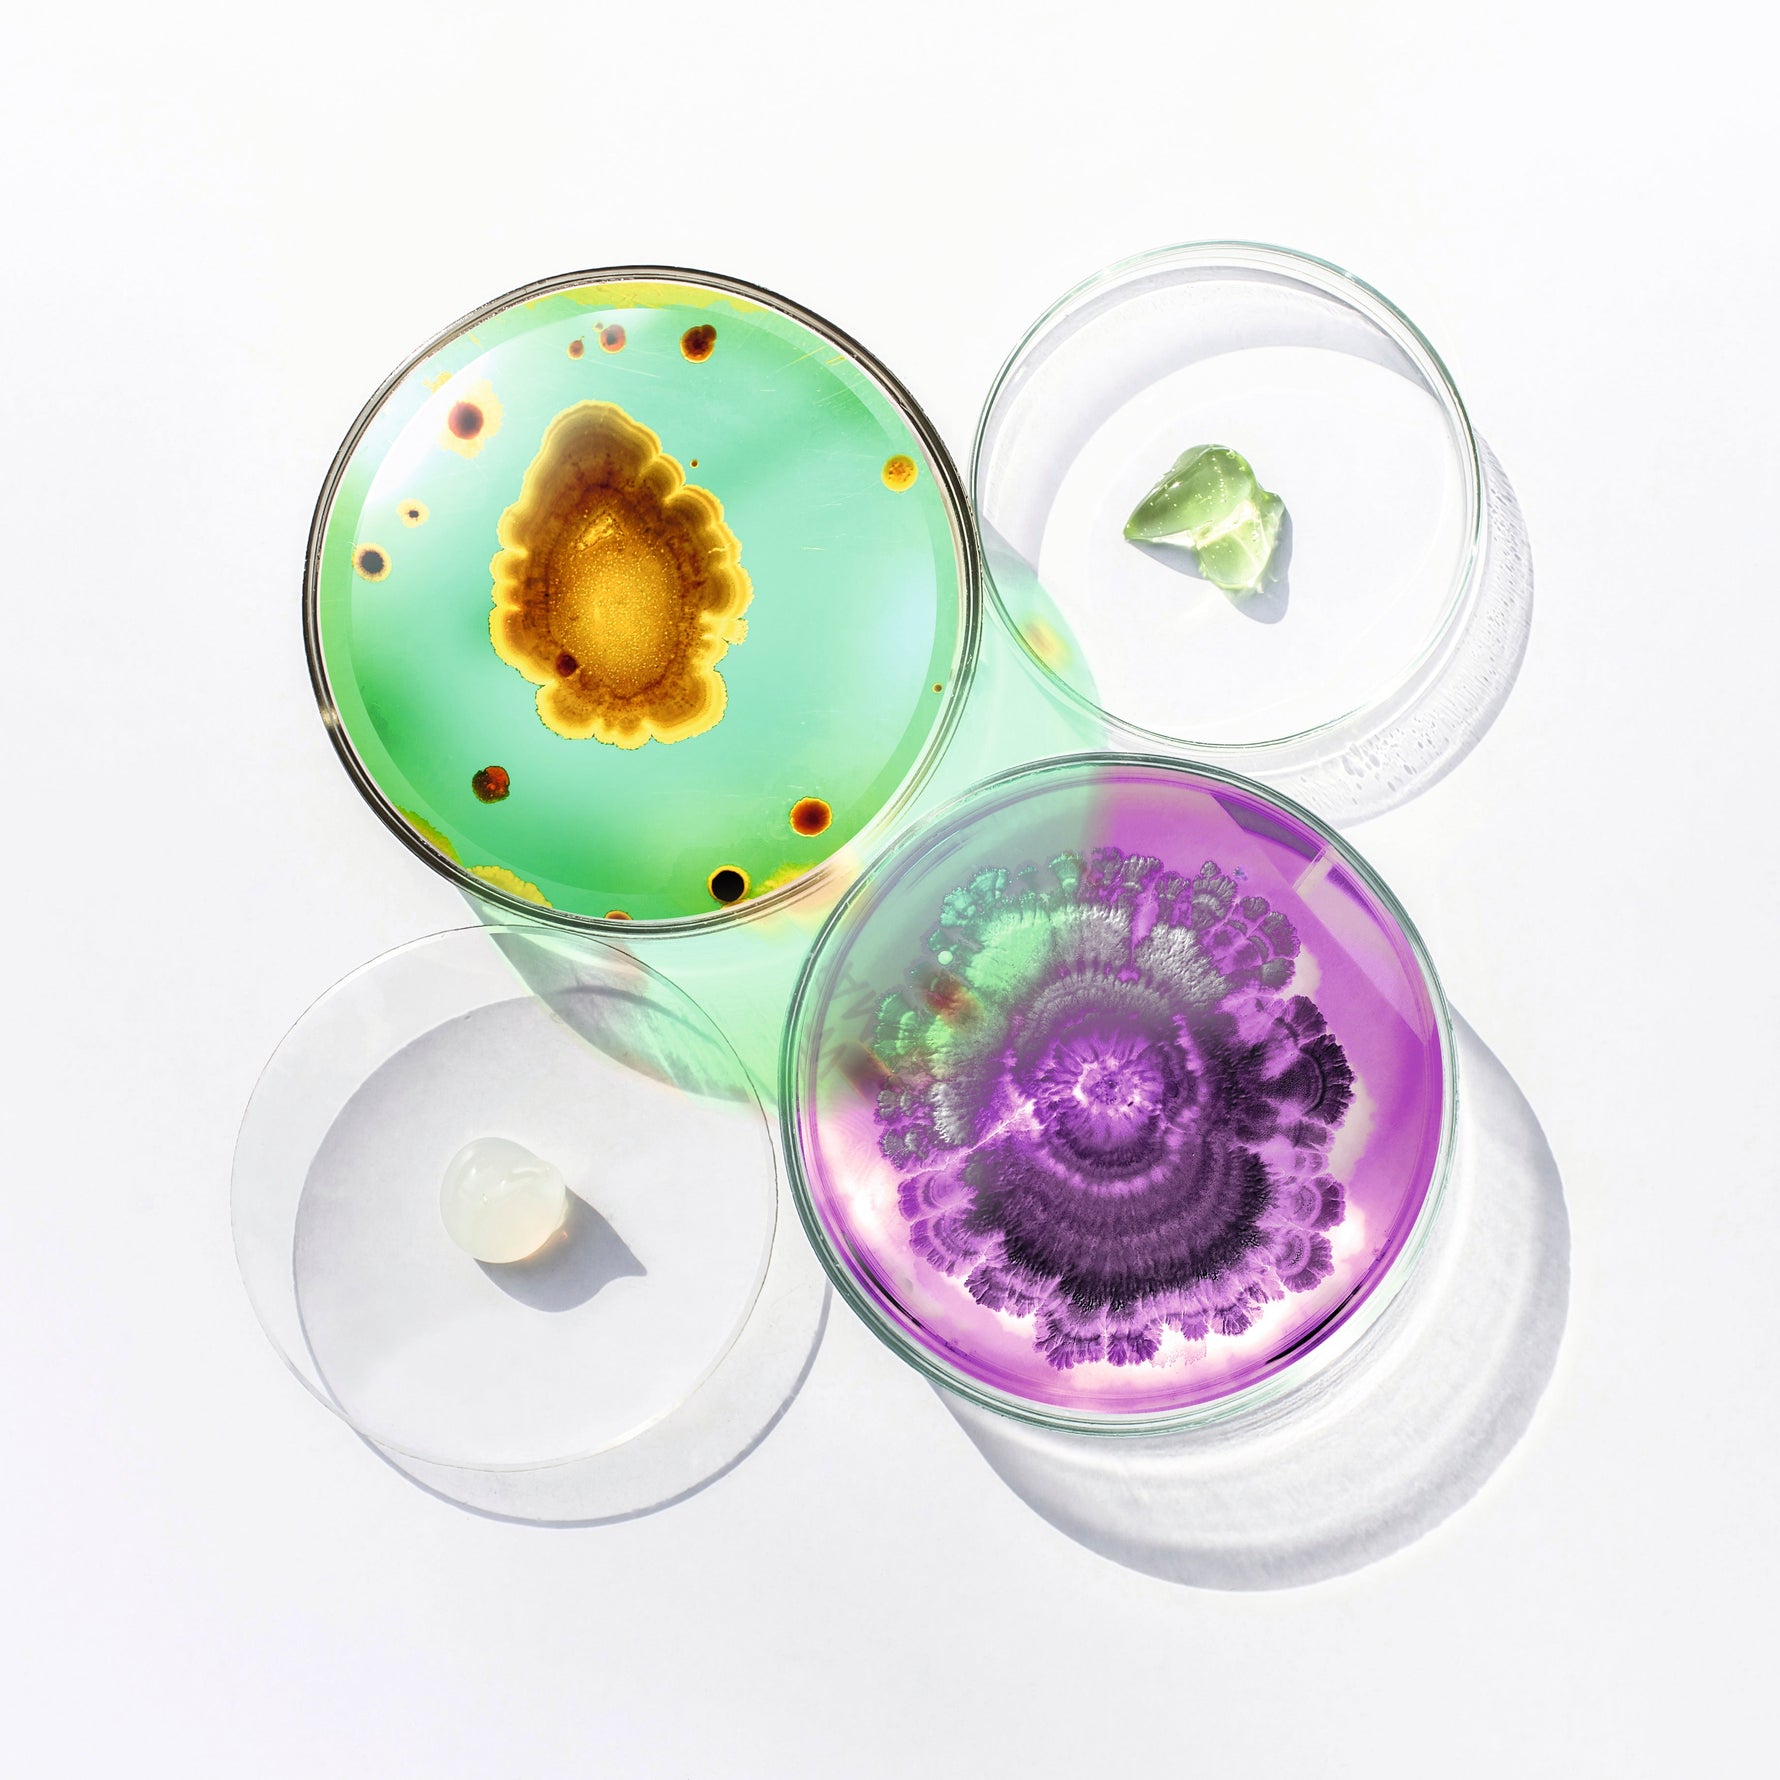

Tolle Qualität und super Service
„Die Produkte sind nicht nur hochwertig, sondern auch sanft zur Haut. Besonders begeistert bin ich vom Kundenservice – freundlich, schnell und hilfsbereit. So macht Online-Shopping wirklich Spaß.“

Wenig auf Lager
Vorraussichtliche Lieferung : Februar 11 and Februar 13.
Ein hydratisierendes und aufpolsterndes Serum für empfindliche Haut, welches die Zeichen der Hautalterung bekämpft, ohne eine Reaktion der Immunfunktion auszulösen.
Verbessert die Zeichen der Hautalterung bei empfindlichen Hauttypen.
110,00 €
Einzelpreis 366,67 € pro 100ml

Entferne Schmutz, überschüssiges Öl und Make-up mit einem sanften Gesichtsreiniger, der zu deinem Hauttyp passt. Die Reinigung ist die Basis jeder Pflegeroutine und bereitet die Haut optimal auf die nächsten Schritte vor
Nach der Reinigung hilft ein Toner, den pH-Wert der Haut zu balancieren und letzte Rückstände zu entfernen. Alternativ (oder zusätzlich, je nach Hauttyp und Bedarf) kann ein sanftes Peeling ein- bis zweimal pro Woche abgestorbene Hautzellen entfernen und das Hautbild verfeinern
Trage eine zum Hauttyp passende Feuchtigkeitspflege auf, um die Haut zu hydratisieren und die natürliche Schutzbarriere zu stärken. Morgens sollte die Pflege idealerweise einen Lichtschutzfaktor enthalten, abends reicht eine klassische Feuchtigkeitscreme





ROQ Cosmetics
Mit einem kleinen, engagierten Team legt ROQ Cosmetics besonderen Wert auf Qualität, Wirksamkeit und Transparenz. Die Produktpalette richtet sich an Menschen, die Wert auf gesunde, effektive und nachhaltige Pflege legen. Im Mittelpunkt stehen dabei natürliche Inhaltsstoffe und moderne Technologien, die Hautgesundheit und Wohlbefinden unterstützen.
Ja, alle Produkte von ROQ Cosmetics sind vegan und werden ohne Tierversuche hergestellt. Das Unternehmen legt großen Wert auf ethische und nachhaltige Produktionsstandards.
Bestellungen im ROQ Cosmetics Onlineshop werden in der Regel innerhalb von 1–3 Werktagen versendet. Die Lieferung erfolgt deutschlandweit und ist ab einem bestimmten Bestellwert versandkostenfrei.
Im ROQ Cosmetics Shop stehen dir verschiedene sichere Zahlungsmethoden zur Verfügung, darunter Kreditkarte, PayPal, Sofortüberweisung und Kauf auf Rechnung. Die verfügbaren Optionen werden dir im Checkout angezeigt und sind einfach und bequem auswählbar
Du hast das Recht, deine Bestellung innerhalb von 14 Tagen nach Erhalt ohne Angabe von Gründen zu widerrufen. Voraussetzung ist, dass die Produkte unbenutzt und in der Originalverpackung zurückgesendet werden. Die Rücksendekosten trägst du selbst. Nach Eingang und Prüfung der Rücksendung erhältst du eine Rückerstattung über das ursprünglich verwendete Zahlungsmittel